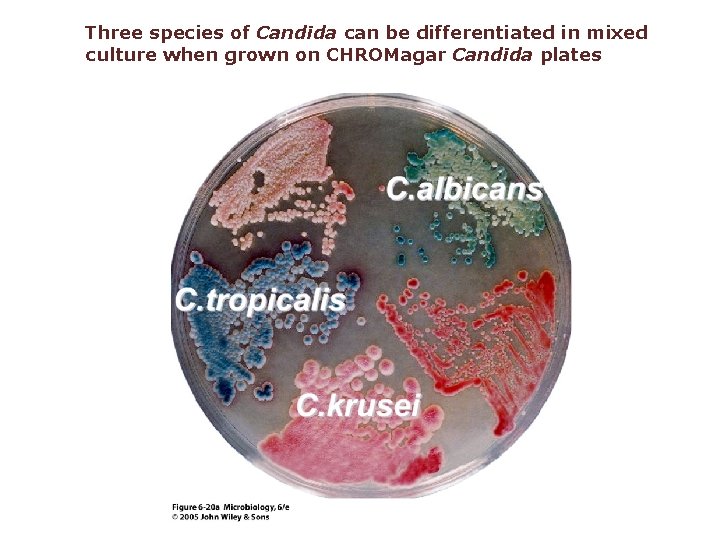
Three species of Candida can be differentiated in mixed culture when grown on CHROMagar
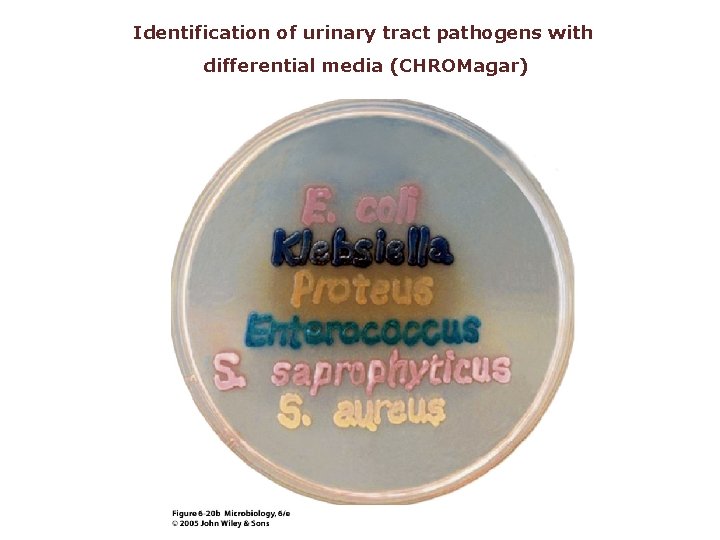
Identification of urinary tract pathogens with differential media (CHROMagar)
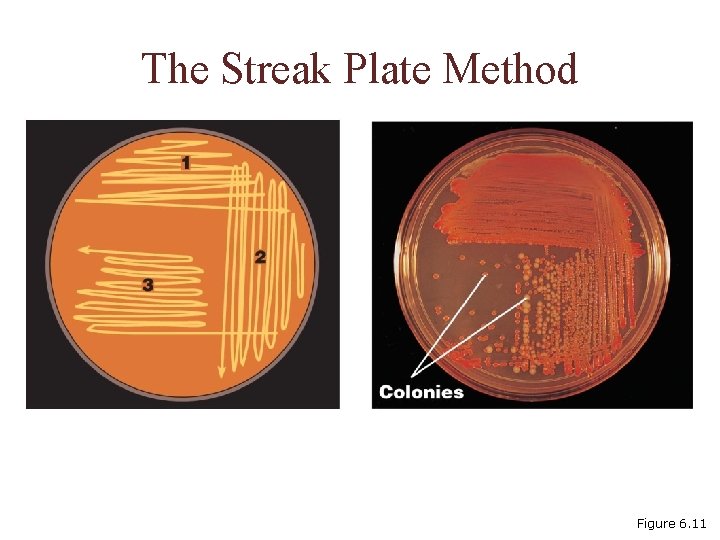
The Streak Plate Method Figure 6. 11
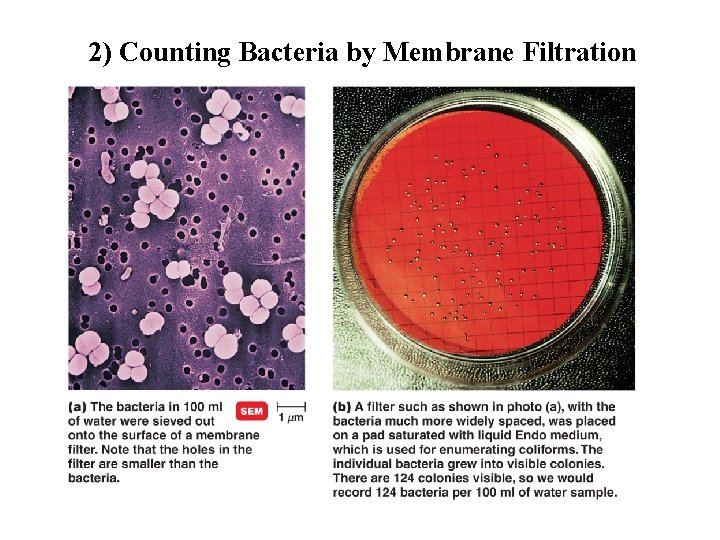
2) Counting Bacteria by Membrane Filtration
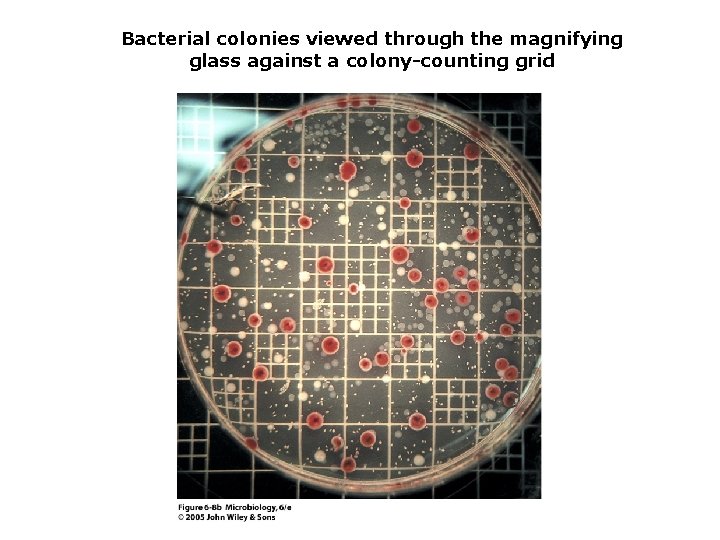
Bacterial colonies viewed through the magnifying glass against a colony-counting grid
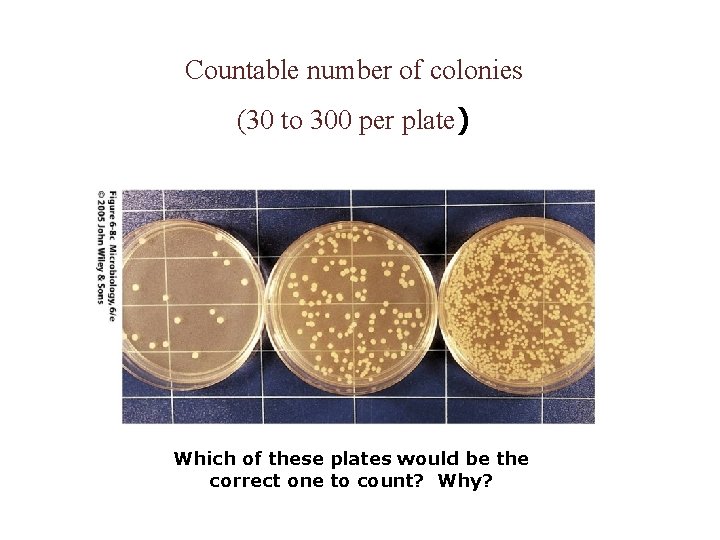
Countable number of colonies (30 to 300 per plate) Which of these plates would

Chapter 5 Microbial Nutrition and Culture contd Siti

Chapter 5 Microbial Nutrition and Culture cont’d Siti Sarah Jumali (ext 2123) Room 3/14 sarah_jumali 84@hotmail. com

Microbial Growth Requirements

The Requirements for Growth PHYSICAL REQUIREMENTS – Temperature – p. H – Oxygen – Hydrostatic Pressure – Osmotic pressure CHEMICAL REQUIREMENTS (NUTRITIONAL FACTORS) – Carbon – Nitrogen, sulfur, and phosphorous – Trace elements – Oxygen – Organic growth factor

Physical Factors Required for Bacterial Growth 1) p. H • • Optimum p. H: the p. H at which the microorganism grows best (e. g. p. H 7) Most bacteria grow between p. H 6. 5 and 7. 5 Molds and yeasts grow between p. H 5 and 6 According to their tolerance for acidity/alkalinity, bacteria are classified as: Acidophiles (acid-loving): grow best at p. H 0. 1 -5. 4 Neutrophiles: grow best at p. H 5. 4 to 8. 0 Alkaliphiles (base-loving): grow best at p. H 7. 0 -11. 5

2) Temperature • According to their growth temperature range, bacteria can be classified as: Psychrophiles : grow best at 15 -20 o. C Psychrotrophs : grow between 0°C and 20– 30°C Mesophiles : grow best at 25 -40 o. C Thermophiles : grow best at 50 -60 o. C Typical Growth Rates and Temperature – Minimum growth temperature: lowest temp which species can grow – Optimum growth temperature: temp at which the species grow best – Maximum growth temperature: highest temp at which grow is possible


Food Preservation Temperatures

3) Oxygen • Aerobes: require oxygen to grow • Obligate aerobes: must have free oxygen for aerobic respiration (e. g. Pseudomonas) • Anaerobes: do not require oxygen to grow • Obligate anaerobes: killed by free oxygen (e. g. Bacteroides) • Microaerophiles: grow best in presence of small amount of free oxygen • Capnophiles: carbon-dioxide loving organisms that thrive under conditions of low oxygen • Facultative anaerobes: carry on aerobic metabolism when oxygen is present, but shift to anaerobic metabolism when oxygen is absent • Aerotolerant anaerobes: can survive in the presence of oxygen but do not use it in their metabolism • Obligate: organism must have specified environmental condition • Facultative: organism is able to adjust to and tolerate environmental condition, but can also live in other conditions

Patterns of Oxygen Use

4) Hydrostatic Pressure • Water in oceans and lakes exerts pressure exerted by standing water, in proportion to its depth • Pressure doubles with every 10 meter increase in depth • Barophiles: bacteria that live at high pressures, but die if left in laboratory at standard atmospheric pressure

5) Osmotic Pressure • Environments that contain dissolved substances exert osmotic pressure, and pressure can exceed that exerted by dissolved substances in cells • Hyperosmotic environments: cells lose water and undergo plasmolysis (shrinking of cell) • Hypoosmotic environment: cells gain water and swell and burst

Plasmolysis

Halophiles • Salt-loving organisms which require moderate to large quantities of salt (sodium chloride) • Membrane transport systems actively transport sodium ions out of cells and concentrate potassium ions inside • Why do halophiles require sodium? 1) Cells need sodium to maintain a high intracellular potassium concentration for enzymatic function 2) Cells need sodium to maintain the integrity of their cell walls

Responses to Salt

The Great Salt Lake in Utah

Chemical Requirement: Nutritional Factors 1. 2. 3. 4. Carbon sources Nitrogen sources Sulfur and phosphorus Trace elements (e. g. copper, iron, zinc, and cobalt) 5. Vitamins (e. g. folic acid, vitamin B-12, vitamin K)

Chemical Requirements • Carbon – Structural organic molecules, energy source – Chemoheterotrophs use organic carbon sources – Autotrophs use CO 2

Chemical Requirements • Nitrogen – In amino acids and proteins – Most bacteria decompose proteins – Some bacteria use NH 4+ or NO 3– – A few bacteria use N 2 in nitrogen fixation

Chemical Requirements • Sulfur – In amino acids, thiamine, and biotin – Most bacteria decompose proteins – Some bacteria use SO 42– or H 2 S • Phosphorus – In DNA, RNA, ATP, and membranes – PO 43– is a source of phosphorus

Chemical Requirements • Trace elements – Inorganic elements (mineral) required in small amounts – Usually as enzyme cofactors – Ex: iron, molybdenum, zinc • Buffer – To neutralize acids and maintain proper p. H – Peptones and amino acids or phosphate salts may act as buffers

Organic Growth Factors • Organic compounds obtained directly from the environment • Ex: Vitamins, amino acids, purines, and pyrimidines

Preparation of Culture Media • Culture medium: Nutrients prepared for microbial growth • Sterile: No living microbes • Inoculum: Introduction of microbes into medium • Culture: Microbes growing in/on culture medium

Agar • Complex polysaccharide • Used as solidifying agent for culture media in Petri plates, slants, and deeps • Generally not metabolized by microbes • Liquefies at 100°C • Solidifies at ~40°C

Types of Culture Media • Natural Media: In nature, many species of microorganisms grow together in oceans, lakes, and soil and on living or dead organic matter • Synthetic medium: A medium prepared in the laboratory from material of precise or reasonably welldefined composition • Complex medium: contains reasonably familiar material but varies slightly in chemical composition from batch to batch (e. g. peptone, a product of enzyme digestion of proteins)

Types of Culture Media Type of Media Purpose Chemically Defined Growth of chemoheterotrophs and photoautotrophs: microbiological assays Complex Growth of most chemoheterotrophic organisms Reducing Growth of obligate an. O 2 Selective Suppresion of unwanted microbes; encouraging desired microbes Differential Differentiation of colonies of desired microbes from others Enrichment Similar to selective media but designed to increase numbers of desired microbes to detectable levels.

Culture Media • Chemically defined media: Exact chemical composition is known • Complex media: Extracts and digests of yeasts, meat, or plants – Nutrient broth – Nutrient agar



Selective, Differential, and Enrichment Media • Selective medium: encourages growth of some organisms but suppresses growth of others (e. g. antibiotics) • Differential medium: contains a constituent that causes an observable change (e. g. Mac. Conkey agar) • Enrichment medium: contains special nutrients that allow growth of a particular organism that might not otherwise be present in sufficient numbers to allow it to be isolated and identified

Selective Media • Suppress unwanted microbes and encourage desired microbes • Ex: Sabouraud’s Dextrose Agar: used to isolate fungi, has a p. H of 5. 6, outgrow most of bacteria Differential Media Make it easy to distinguish colonies of different microbes. Ex: Blood Agar: bacteria that can lysed blood cells causing a clear areas around the colonies.
Three species of Candida can be differentiated in mixed culture when grown on CHROMagar Candida plates
Identification of urinary tract pathogens with differential media (CHROMagar)

Enrichment Media • Encourages growth of desired microbe • Assume a soil sample contains a few phenol-degrading bacteria and thousands of other bacteria – Inoculate phenol-containing culture medium with the soil, and incubate – Transfer 1 ml to another flask of the phenol medium, and incubate – Only phenol-metabolizing bacteria will be growing

Culturing Bacteria • Culturing of bacteria in the laboratory presents two problems: 1. A pure culture of a single species is needed to study an organism’s characteristics 2. A medium must be found that will support growth of the desired organism

Obtaining Pure Cultures • Pure culture: a culture that contains only a single species or strain of organism • A colony is a population of cells arising from a single cell or spore or from a group of attached cells • A colony is often called a colony-forming unit (CFU) • The streak plate method is used to isolate pure cultures

The Streak Plate Method uses agar plates to prepare pure cultures
The Streak Plate Method Figure 6. 11

Anaerobic Culture Methods • Reducing media – Contain chemicals (thioglycolate or oxyrase) that combine O 2 – Heated to drive off O 2

Anaerobic Jar Figure 6. 6

To culture obligate anaerobes, all molecular oxygen must be removed and kept out of medium. Agar plates are incubated in sealed jars containing chemical substances that remove oxygen and generate carbon dioxide or water

Anaerobic Transfer

An Anaerobic Chamber Figure 6. 7

Capnophiles • Microbes that require high CO 2 conditions • CO 2 packet • Candle jar

Preserved Cultures • 1. 2. 3. • To avoid risk of contamination and to reduce mutation rate, stock culture organisms should be kept in a preserved culture, a culture in which organisms are maintained in a dormant state Lyophilization (freeze-drying): Frozen (– 54° to – 72°C) and dehydrated in a vacuum Deep Freezing: – 50° to – 95°C Refrigeration Reference culture (type culture): a preserved culture that maintains the organisms with characteristics as originally defined

CHAPTER 6: MICROBIAL GROWTH

Growth and Cell Division • Microbial growth is defined as the increase in the number of cells, which occurs by cell division • Binary fission (equal cell division): A cell duplicates its components and divides into two cells • Septum: A partition that grows between two daughter cells and they separate at this location • Budding (unequal cell division): A small, new cell develops from surface of exisiting cell and subsequently separates from parent cell

Binary Fission

Binary Fission

Thin section of the bacterium Staphylococcus, undergoing binary fission

Budding in Yeast

Phases of Growth • Consider a population of organisms introduced into a fresh, nutrient medium • Such organisms display four major phases of growth in batch culture: 1. 2. 3. 4. The lag phase The logarithmic phase The stationary phase The death phase


The Lag Phase • Organisms do not increase significantly in number • They are metabolically active • Grow in size, synthesize enzymes, and incorporate molecules from medium • Produce large quantities of energy in the form of ATP

The Log Phase • Organisms have adapted to a growth medium • Growth occurs at an exponential (log) rate • The organisms divide at their most rapid rate • a regular, genetically determined interval (generation time)

Synchronous growth: A hypothetical situation in which the number of cells in a culture would increase in a stair-step pattern, dividing together at the same rate Nonsynchronous growth: A natural situation in which an actual culture has cell dividing at one rate and other cells dividing at a slightly slower rate

Stationary Phase 1) Cell division decreases to a point that new cells are produced at same rate as old cell die. 2) The number of live cells stays constant. Decline (Death) Phase 1) Condition in the medium become less and less supportive of cell division 2) Cell lose their ability to divide and thus die 3) Number of live cells decreases at a logarithmic rate

Microbes growing continuously in a chemostat

Measuring Microbial Growth Direct Methods Indirect Methods • • • Turbidity • Metabolic activity • Dry weight Plate counts Filtration MPN Direct microscopic count

Direct Methods 1) Plate Count • Must perform - Serial Dilutions - Pour plate or Spread Plate Method • often reported as colony-forming units (CFU) Serial Dilution

Plate Counts Figure 6. 17

Plate Counts • After incubation, count colonies on plates that have 25– 250 colonies (CFUs) Figure 6. 16
2) Counting Bacteria by Membrane Filtration

3) The Most Probable Number (MPN) Method • Method to estimate number of cells • Multiple tube MPN test • Count positive tubes • Compare with a statistical table.

4) Direct Microscopic Counts • Another way to measure bacterial growth by: 1) Petroff-Hausser counting chamber 2) Colony counting chamber • In Petroff-Hausser counting chamber, bacterial suspension is introduced onto chamber with a calibrated pipette • Microorganisms are counted in specific calibrated areas • Number per unit volume is calculated using an appropriate formula

The Petroff-Hausser Counting Chamber

Direct Microscopic Count

Counting colonies using a bacterial colony counter
Bacterial colonies viewed through the magnifying glass against a colony-counting grid
Countable number of colonies (30 to 300 per plate) Which of these plates would be the correct one to count? Why?

Indirect Methods 1) Turbidity • Practical way of monitoring bacterial growth. • Measure turbidity using spectrophotometer A Spectrophotometer: This instrument can be used to measure bacterial growth by measuring the amount of light that passes through a suspension of cells

Turbidity

Turbidity The less light transmitted, the more bacteria in sample.

2) Metabolic Activity • Assuming the amount of a certain metabolic product, ex acids, CO 2 produced = direct propotion of no of bacteria present 3) Dry Weight • For filamentous bacteria and molds • Apply filtration of amount of broth culture on filter paper and dried in a dessicator • Weight of dried culture = direct propotion of no of bacteria present

Biosafety Levels • 1: No special precautions • 2: Lab coat, gloves, eye protection • 3: Biosafety cabinets to prevent airborne transmission • 4: Sealed, negative pressure – Exhaust air is filtered twice

Biosafety Level 4 (BSL-4) Laboratory

Questions?
- Slides: 76